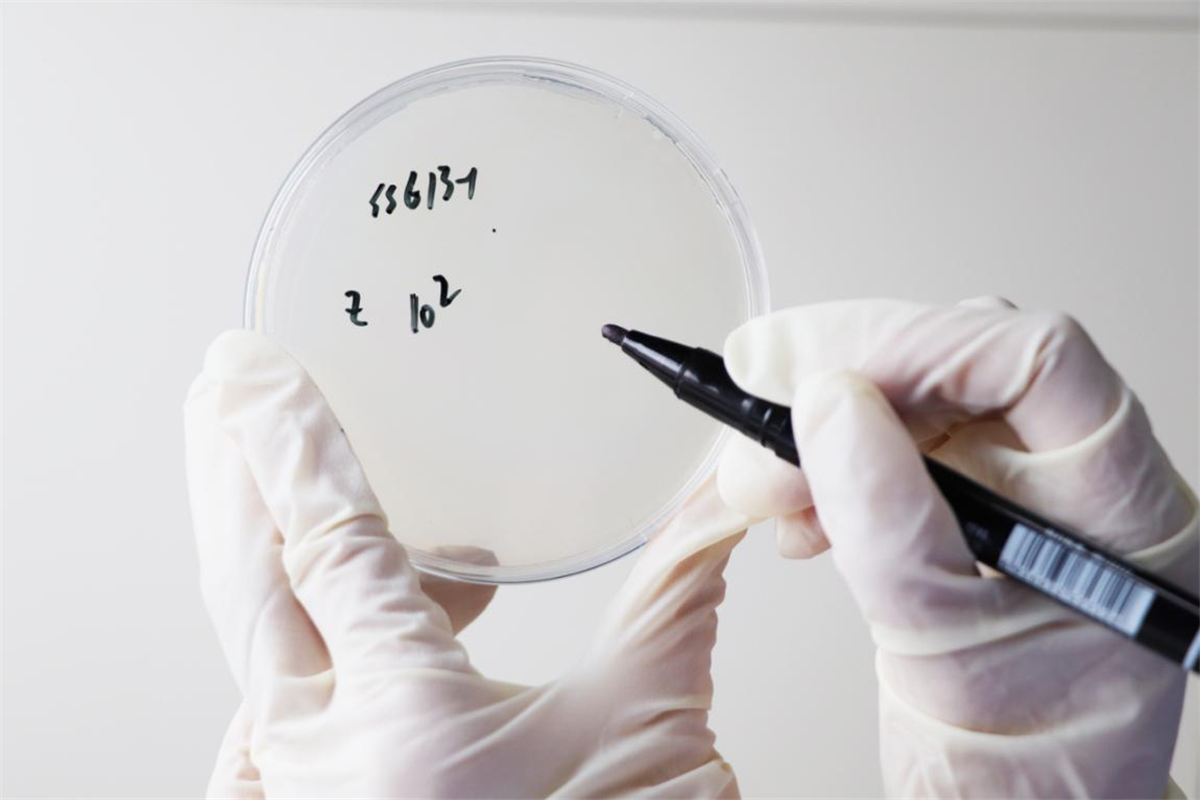

月饼的科仪“体检”之旅
说起体检,大家可能并不陌生,但是让一枚月饼去做"体检",可能很多人会感到很疑惑,月饼和体检也能扯上关系吗?
通俗的讲,所谓月饼"体检"就是月饼检测,与我们通常的体检过程大同小异。今天,小科就为大家介绍一下一枚月饼在科仪阳光的"体检"之旅。
“我”就是那块月饼↑
近期,各色月饼争先上市,品质及食品质量安全应如何得到保障呢?
为保证自身安全“我”来到了科仪阳光检测。
首先到的是客服部——客服部的老师们很专业,了解了“我”的需求(生产许可、型式检验、商超要求)后,依据国家法律法规和标准要求,为“我”提供不同的“体检套餐”:
第一步:受理“体检”任务(因时至中秋,这次“我”享受了VIP待遇——“月饼体检”专用绿色通道);
第二步:挂号,先进的实验室信息管理系统对“我”进行了唯一性编码(样品编号+条形码),同时采集“我”的样品照片,这个编码就是“我”在实验室整个检测过程的身份证号码,避免和其他同伴混淆。
第三步:下发“诊断参数(检测项目)”至各专业科室(这个工作是最关键的一环,实验室要熟悉“我”的标准GB/T19855-2015《月饼》、GB7099-2015《糕点》、相关法律法规及其检测方法标准;
第四步:专人送“我”去候诊区(转交月饼至样品室“候诊”)。
在“候诊室”——样品室,进行一些准备工作,以方便“我”进专业科室顺利体检,主要内容如下:
首先通过LIMS系统(实验室信息管理系统)扫码入库,进入属于“我”的等待区域(待检区);
其次要进行体检前期准备工作——样品制备:根据不同的检测项目,制备要求不同(皮馅分离制样1份,混合制样1份);切记,微生物检测是不能被污染的,所以要有专门的样品,不能制备。
另外,一定要重点关注“我”在等待检测期间的储存环境(样品储存),一定要为“我”提供标签标识的环境条件,否则体检结果可能会有影响。所以,样品室的温湿度条件一定要控制并做好记录。
接下来进入专业诊断科室
“诊断”第一站——微生物室
微生物项目容易受到外界环境因素的影响,所以要第一时间进入实验室,作为第一站的“体检”项目。
检测参数包括菌落总数、大肠菌群、霉菌、沙门氏菌、金黄色葡萄球菌。
微生物是衡量食品卫生质量的重要指标,也是判定被检食品能否食用的科学依据之一;通过食品微生物检验,能够正确的评价食品被细菌污染的程度。
“诊断”第二站——理化室
理化室的检测主要是品质指标,参数包括:感官、干燥失重、蛋白质、酸价、过氧化值。这几类指标也比较容易受外界环境的影响,故而也必须在时效范围内完成检测。
感官是对食品的色、香、味和外观形态进行综合性的鉴别和评价;
干燥失重即水分,其含量高低和微生物的生长及生化反应都有密切的关系;
蛋白质含量主要用来评价食品的营养价值;
酸价、过氧化值是反映食品中油脂氧化、酸败变质程度的指标。当食品产生俗称的“哈喇味”时,就说明其中的油脂已经严重酸败,不宜食用。
“诊断”第三站
色谱室——这里主要进行食品添加剂的检测。
例如可以让食品延迟保质期的防腐剂(苯甲酸、山梨酸、脱氢乙酸);让食品更美味的甜味剂(糖精钠、甜蜜素、安赛蜜);可以让食品外观更美观的食用色素(柠檬黄、日落黄)等。这些添加剂在国家标准允许的范围内使用是安全的,超限量使用可能会对人体健康产生不利影响。
光谱室——检测项目主要是铅、砷、铝的残留量。
铅和砷属于重金属污染物指标,主要来源于谷物生长过程中土壤、空气,灌溉水中的重金属以及生产加工过程中带入的重金属污染。
长期食用重金属超标的食品,会对人体健康产生不良影响。月饼中铝残留量超标主要是因为生产企业过量使用了含硫酸铝钾、硫酸铝铵等成分的膨松剂,食用过多会影响脑细胞和中枢神经。
“诊断”最后一站——标签组
标签是消费者了解食品信息最直接的途径。
一个合格的标签,既可以让消费者充分了解产品的相关信息(如配料、产地、营养成分等),维护消费者对产品信息的知情权;也可以帮助生产企业规避风险,降低成本。
经过各科室的精细检查,本次科仪阳光检测“体检”之旅来到了最后一个环节-----体检报告。
报告组在整个检测过程中相当于一个组装部,各科室的“体检数据”依据相关产品标准、卫生标准、法律法规,通过实验室LIMS(实验室信息管理系统)进行汇总和评价,“体检报告”经过3级审核及签发,在资质允许的范围内,加盖资质章,一份具有法律性,科学性、公正性的报告就生成了。
这便是“我”一枚月饼,在科仪阳光检测进行体检的整个过程。
一份客观、科学、公正的食品检验报告,是生产经营者和消费者之间建立食品质量安全信任的桥梁;可以为企业生产过程中的食品安全质量控制水平的提升提供依据;是政府监管部门实施食品监管最有力的支撑;是营造放心安全的食品消费环境的重要一环!